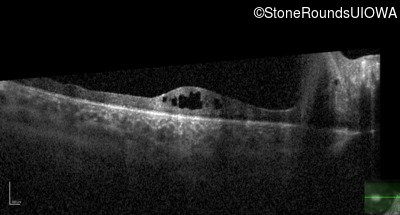
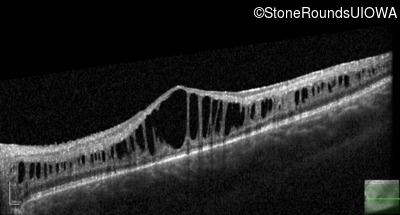

Case
SR1950
Student Mode
XL Retinoschisis (IIIB1)
Male
Male
Hidden
SR1950
Student Mode
XL Retinoschisis (IIIB1)
Male
Male
Highlighted Images
| Age at visit: 3 years | OD | OS |
|---|---|
| Age at visit: 3 years |
| OD | OS | ||
|---|---|---|---|
| Age at visit: 3 years (Visit 2) |
| OD | OS | ||
|---|---|---|---|
Diagnosis & molecular findings
| Disease | Gene | Allele 1 variant(s) | Allele 2 variant(s) | Inheritance mode |
|---|---|---|---|---|
| XL Retinoschisis | RS1 | Ser221 Ins1aG | XL |